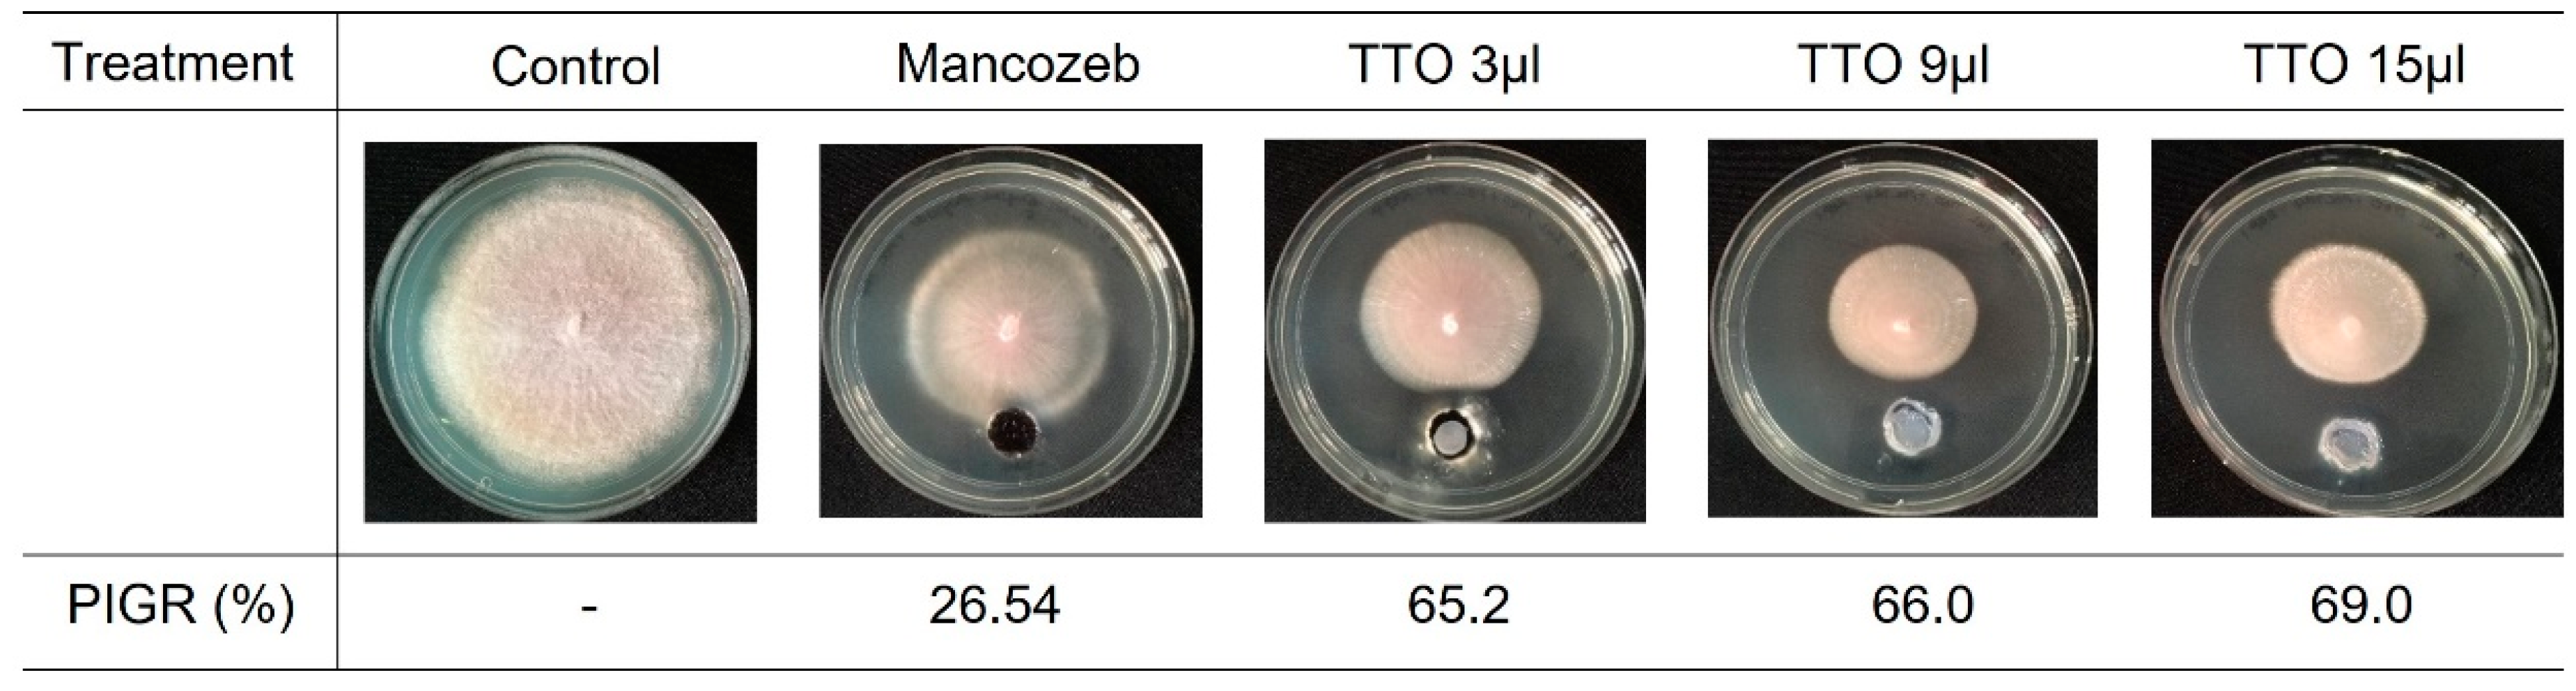
Molecules 28 04456 g001 Molecules 28 04456 g001
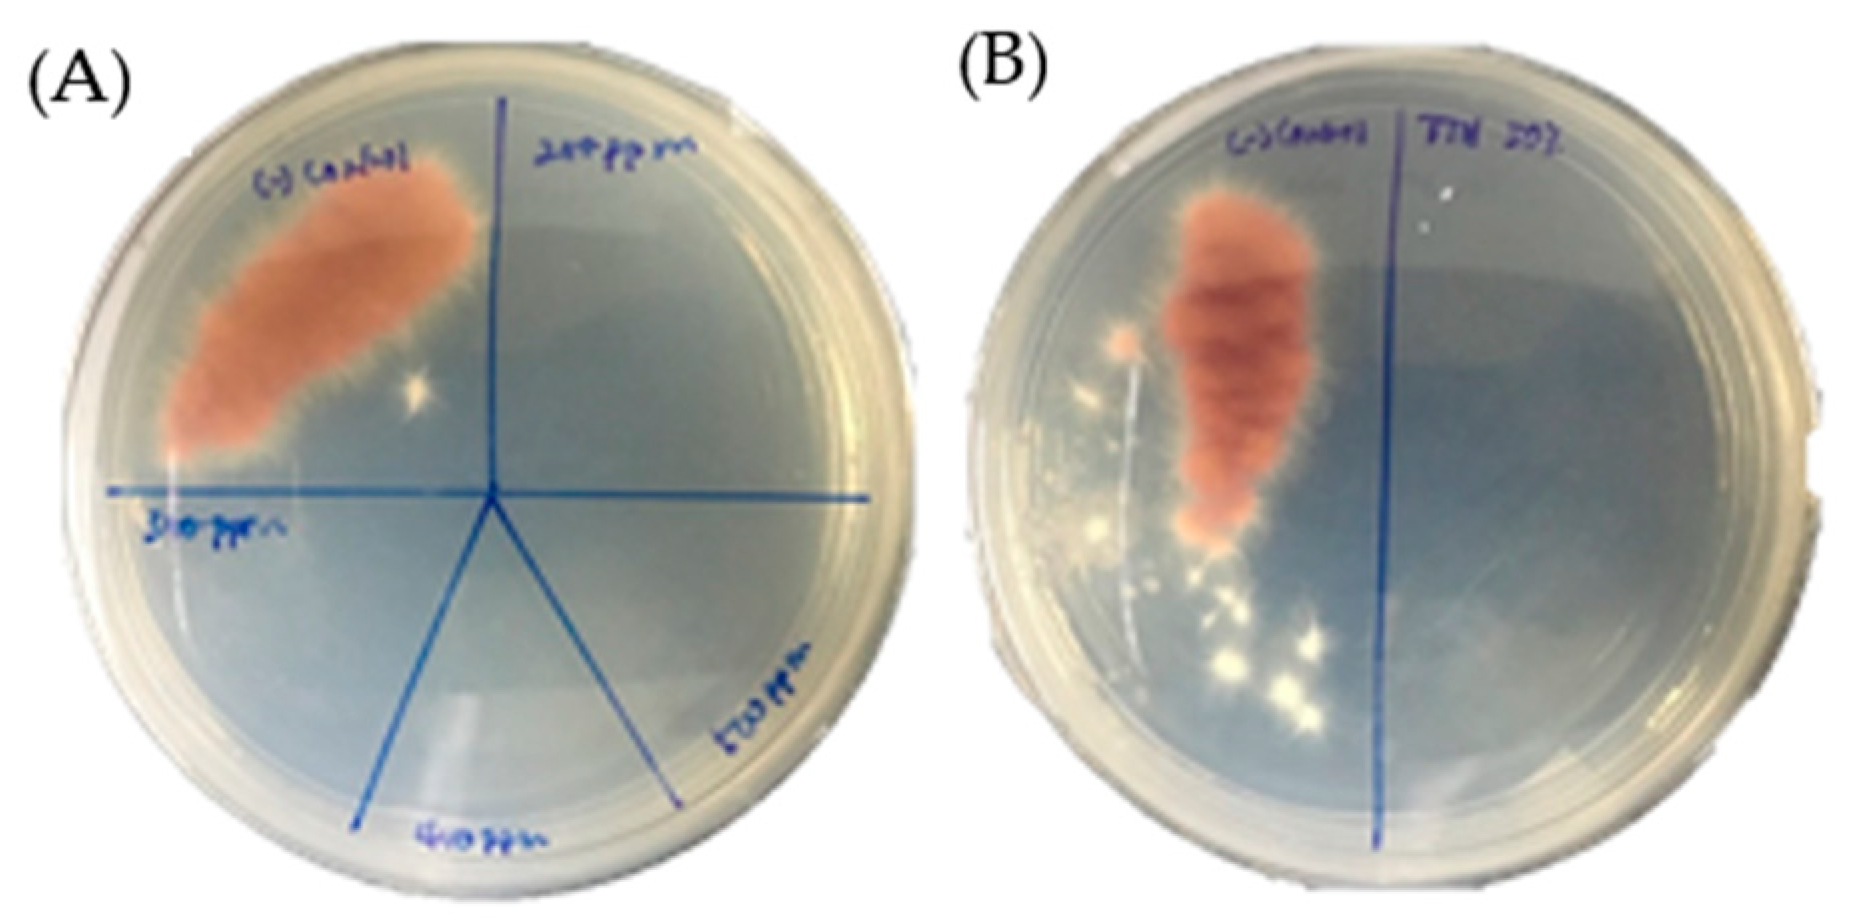
Molecules 28 04456 g002 Molecules 28 04456 g002

Antifungal Potential of Melaleuca alternifolia against Fungal Pathogen Fusarium oxysporum f. sp. cubense Tropical Race 4
Abstract
1. Introduction
2. Results
2.1. In Vitro Antifungal Activity of Tea Tree Essential Oil and Hydrosol against Foc TR4
2.2. In Vivo Antifungal Activity of Tea Tree Essential Oil and Hydrosol against Foc TR4
2.3. Yield and Composition of Tea Tree Essential Oil
2.4. Yield and Composition of Tea Tree Hydrosol
3. Discussion
4. Materials and Methods
4.1. Plant and Fungal Materials
4.2. Isolation of Essential Oil and Hydrosol
4.3. Agar Well Diffusion Assay
4.4. Determination of Minimum Inhibitory Concentration (MIC) and Minimum Fungicidal Concentrations (MFC)
4.5. Spore Germination Assay
4.6. In Vivo Antifungal Assay
4.7. Gas Chromatography–Mass Spectrometry Analysis (GC/MS) of Tea Tree Essential Oil
4.8. Liquid Chromatography–Mass Spectrometry Analysis (LC/MS) Tea Tree Hydrosol
4.9. Statistical Analysis
5. Conclusions
Supplementary Materials
Author Contributions
Funding
Institutional Review Board Statement
Informed Consent Statement
Data Availability Statement
Acknowledgments
Conflicts of Interest
Sample Availability
References
- Ploetz, R.C. Fusarium wilt of banana. Phytopathology 2015, 105, 1512–1521. [Google Scholar] [CrossRef] [PubMed]
- Maymon, M.; Sela, N.; Shpatz, U.; Galpaz, N.; Freeman, S. The origin and current situation of Fusarium oxysporum f. sp. cubense Tropical Race 4 in Israel and the Middle East. Sci. Rep. 2020, 10, 1590. [Google Scholar] [CrossRef] [PubMed]
- Staver, C.; Pemsl, D.E.; Scheerer, L.; Perez Vicente, L.; Dita, M. Ex Ante Assessment of Returns on Research Investments to Address the Impact of Fusarium Wilt Tropical Race 4 on Global Banana Production. Front. Plant Sci. 2020, 11, 844. [Google Scholar] [CrossRef] [PubMed]
- Pegg, K.G.; Coates, L.M.; O’Neill, W.T.; Turner, D.W. The epidemiology of Fusarium wilt of banana. Front. Plant Sci. 2019, 10, 1395. [Google Scholar] [CrossRef]
- Chen, A.; Sun, J.; Matthews, A.; Armas-Egas, L.; Chen, N.; Hamill, S.; Mintoff, S.; Tran-Nguyen, L.T.T.; Batley, J.; Aitken, E.A.B. Assessing variations in host resistance to Fusarium oxysporum f sp. cubense Race 4 in Musa species, with a focus on the subtropical race 4. Front. Microbiol. 2019, 10, 1062. [Google Scholar] [CrossRef]
- Jamil, F.N.; Tang, C.N.; Saidi, N.B.; Lai, K.S.; Baharum, N.A. Fusarium wilt in banana: Epidemics and management strategies. In Horticultural Crops; Baimey, H.K., Hamamouch, N., Kolombia, Y.A., Eds.; IntechOpen: London, UK, 2019; pp. 117–142. [Google Scholar]
- Siamak, S.B.; Zheng, S. Banana Fusarium wilt (Fusarium oxysporum f. sp. cubense) control and resistance, in the context of developing wilt-resistant bananas within sustainable production systems. Hortic. Plant J. 2018, 4, 208–218. [Google Scholar] [CrossRef]
- Cannon, S.; Kay, W.; Kilaru, S.; Schuster, M.; Gurr, S.J.; Steinberg, G. Multi-site fungicides suppress banana Panama disease, caused by Fusarium oxysporum f. sp. cubense Tropical Race 4. PLoS Pathog. 2022, 18, e1010860. [Google Scholar] [CrossRef]
- Bubici, G.; Kaushal, M.; Prigigallo, M.I.; Cabanas, C.G.-L.; Mercado-Blanco, J. Biological control agents against Fusarium wilt of banana. Front. Microbiol. 2019, 10, 616. [Google Scholar] [CrossRef]
- Bazioli, J.M.; Amaral, L.D.S.; Fill, T.P.; Rodrigues, F.E. Insights into Penicillium brasilianum secondary metabolism and its biotechnological potential. Molecules 2017, 22, 858. [Google Scholar] [CrossRef] [PubMed]
- Jamiołkowska, A. Natural compounds as elicitors of plant resistance against diseases and new biocontrol strategies. Agronomy 2020, 10, 173. [Google Scholar] [CrossRef]
- Mohamed, A.A.; El-Hefny, M.; El-Shanhorey, N.A.; Ali, H.M. Foliar application of bio-stimulants enhancing the production and the toxicity of Origanum majorana essential oils against four rice seed-borne fungi. Molecules 2020, 25, 2363. [Google Scholar] [CrossRef]
- Salem, M.Z.M.; Mohamed, A.; Ali, H.; Al Farraj, D. Characterization of phytoconstituents from alcoholic extracts of four woody species and their potential uses for management of six Fusarium oxysporum isolates identified from some plant hosts. Plants 2021, 10, 1325. [Google Scholar] [CrossRef]
- Abbas, A.; Yli-Mattila, T. biocontrol of Fusarium graminearum, a causal agent of fusarium head blight of wheat, and deoxynivalenol accumulation: From in vitro to in planta. Toxins 2022, 14, 299. [Google Scholar] [CrossRef]
- Reyes, C.P.; Sabina, S.R.; López-Cabeza, R.; Montelongo, C.G.; Giménez, C.; Jiménez, I.A.; Cabrera, R.; Bazzochi, I.L. Antifungal potential of Canarian plant extracts against high-risk phytopathogens. Plants 2022, 11, 2988. [Google Scholar] [CrossRef]
- Santra, H.K.; Banerjee, D. Natural products as fungicide and their role in crop protection. Nat. Bioact. Prod. Sustain. Agri. 2020, 12, 131–219. [Google Scholar]
- Carson, C.F.; Hammer, K.A.; Riley, T.V. Melaleuca alternifolia (tea tree) oil: A review of antimicrobial and other medicinal properties. Clin. Microbiol. Rev. 2006, 19, 50–62. [Google Scholar] [CrossRef] [PubMed]
- Chidi, F.; Bouhoudanab, A.; Khaddor, M. Antifungal effect of the tea tree essential oil (Melaleuca alternifolia) against Penicillium griseofulvum and Penicillium verrucosum. J. King Saud Univ. Sci. 2020, 32, 2041–2045. [Google Scholar] [CrossRef]
- Dalio, R.J.D.; Maximo, H.J.; Roma-Almeida, R.; Barretta, J.N.; José, E.M.; Vitti, A.J.; Blachinsky, D.; Reuveni, M.; Pascholati, S.F. Tea tree oil induces systemic resistance against Fusarium wilt in banana and Xanthomonas infection in tomato plants. Plants 2020, 9, 1137. [Google Scholar] [CrossRef]
- Reuveni, M.; Barbier, M.; Viti, A.J. Essential tea tree oil as a tool to combat black Sigatoka in banana. Outlooks Pest Manag. 2020, 31, 180–186. [Google Scholar] [CrossRef]
- Yue, Q.; Shao, X.; Wei, Y.; Jiang, S.; Xu, F.; Wang, H.; Gao, H. Optimized preparation of tea tree oil complexation and their antifungal activity against Botrytis cinerea. Postharvest Biol. Tech. 2020, 162, 11114. [Google Scholar] [CrossRef]
- de Groot, A.C.; Schmidt, E. Tea tree oil: Contact allergy and chemical composition. Contact Derm. 2016, 75, 129–143. [Google Scholar] [CrossRef]
- Zatla, A.T.; El Amine Dib, M.; Djabou, N.; Ilias Costa, J.; Muselli, A. Antifungal activities of essential oils and hydrosol extracts of Daucus carota subsp. sativus for the control of fungal pathogens, in particular gray rot of strawberry during storage. J. Essent. Oil Res. 2017, 29, 391–399. [Google Scholar] [CrossRef]
- Belabbes, R.; Dib, M.E.A.; Djabou, N.; Ilias, F.; Tabti, B.; Costa, J.; Muselli, A. Chemical Variability, Antioxidant and Antifungal Activities of Essential Oils and Hydrosol Extract of Calendula arvensis L. from Western Algeria. Chem. Biodivers. 2017, 14, e1600482. [Google Scholar] [CrossRef] [PubMed]
- Paramalingam, P.; Anuar, M.S.K.; Abd Aziz, J.; Saidi, N.B. In vitro evaluation of antifungal activity of selected Malaysian plants against the wilt pathogen of banana, Fusarium oxysporum f.sp. cubense Tropical Race 4. MJS 2021, 40, 16–24. [Google Scholar] [CrossRef]
- Terzi, V.; Morcia, C.; Faccioli, P.; Vale, G.; Tacconi, G.; Malnati, M. In vitro antifungal activity of the tea tree (Melaleuca alternifolia) essential oil and its major components against plant pathogens. Appl. Lett. Microbiol. 2007, 44, 613–618. [Google Scholar] [CrossRef]
- de Andrade Santiago, J.; Cardoso, M.D.G.; Batista, L.R.; Santiago, W.D.; Passamani, F.R.F.; Rodrigues, L.M.A.; Nelson, D.L. Effect of the essential oils from Melaleuca alternifolia, Melaleuca quinquenervia and Backhousia citriodora on the synthesis of ochratoxin A by Aspergillus niger and Aspergillus carbonarius isolated from tropical wine grapes. J. Food Sci. Technol. 2018, 55, 418–2423. [Google Scholar] [CrossRef]
- Krzyśko-Łupicka, T.; Sokół, S.; Piekarska Stachowiak, A. Evaluation of fungistatic activity of eight selected essential oils on four heterogeneous Fusarium isolates obtained from cereal grains in Southern Poland. Molecules 2020, 25, 292. [Google Scholar] [CrossRef] [PubMed]
- Cox, S.D.; Mann, C.M.; Markham, J.L.; Bell, H.C.; Gustafson, J.E.; Warmington, J.R.; Wyllie, S.G. The mode of antimicrobial action of the essential oil of Melaleuca alternifolia (tea tree oil). J. Appl. Microbiol. 2000, 88, 170–175. [Google Scholar] [CrossRef]
- Scorzoni, L.; de Paula ESilva, A.C.; Marcos, C.M.; Assato, P.A.; de Melo, W.C.; de Oliveira, H.C.; Costa-Orlandi, C.B.; Mendes-Giannini, M.J.; Fusco-Almeida, A.M. Antifungal Therapy: New Advances in the Understanding and Treatment of Mycosis. Front. Microbiol. 2017, 8, 36. [Google Scholar] [CrossRef] [PubMed]
- Munusamy, U.; Mohd-Yusuf, Y.; Baharum, N.A.; Zaidi, K.; Othman, R.Y. RT-qPCR profiling of pathogenesis related genes in Musa acuminata cv. ‘Berangan’ seedlings challenged with Fusarium oxysporum f. sp. cubense Tropical Race 4. Pakistan J. Agri. Sci. 2019, 56, 37–42. [Google Scholar] [CrossRef]
- Huang, Y.H.; Wang, R.C.; Li, C.H.; Zuo, C.W.; Wei, Y.R.; Zhang, L.; Yi, G.J. Control of Fusarium wilt in banana with Chinese leek. Eur. J. Plant Pathol. 2012, 134, 87–95. [Google Scholar] [CrossRef]
- Giamperi, L.; Bucchini, A.E.A.; Ricci, D.; Papa, F.; Maggi, F. Essential oil of Achillea ligustica (Asteraceae) as an antifungal agent against phytopathogenic fungi. Nat. Prod. Com. 2018, 13, 9. [Google Scholar] [CrossRef]
- Dhaouadi, S.; Rouissi, W.; Hamdane, A.M.; Hannachi, I.; Nasraoui, B. Antifungal activity of essential oils of Origanum majorana and Lavender angustifolia against Fusarium wilt and root rot disease of melon plants. Tunis. J. Plant Protect. 2018, 13, 39–55. [Google Scholar]
- Rajendrasozhan, S.; Moll, H.E.; Snoussi, M.; Romeilah, R.M.; Shalaby, E.A.; Younes, K.M.; El-Beltagi, H.S. Phytochemical screening and antimicrobial activity of various extracts of aerial parts of Rhanterium epapposum. Processes 2021, 9, 1351. [Google Scholar] [CrossRef]
- Walters, D.R.; Cowley, T.; Weber, H. Rapid Accumulation of Trihydroxy Oxylipins and Resistance to the Bean Rust Pathogen Uromyces fabae Following Wounding in Vicia faba. Ann. Bot. 2006, 97, 779–784. [Google Scholar] [CrossRef] [PubMed]
- Yang, W.; Devaiah, S.P.; Pan, X.; Isaac, G.; Welti, R.; Wang, X. AtPLAI is an acyl hydrolase involved in basal jasmonic acid production and Arabidopsis resistance to Botrytis cinerea. J. Biol. Chem. 2007, 282, 18116–18128. [Google Scholar] [CrossRef] [PubMed]
- Marks, D. Salts of Dihydrojasmonic Acid and Use thereof in Agriculture. European Patent EP 1 740 045 B1. 2005. European Patent Office. Available online: https://data.epo.org/publication-server/document?iDocId=4255725&iFormat=2 (accessed on 10 May 2023).
- Abdul Aziz, J.; Saidi, N.B.; Ridzuan, R.; Mohammad, A.K.S.; Abdul Aziz, M.; Abdul Kadir, M.; Abdullah, N.A.P.; Hussein, S.; Yusoff, H. Chemical profiling of Curcuma aeruginosa Roxb. essential oil and their antimicrobial activity against pathogenic microbes. J. Essent Oil Bear Pl. 2021, 24, 1059–1071. [Google Scholar] [CrossRef]
- Hammer, K.; Carson, C.F.; Riley, T.V. Antifungal activity of the components of Melaleuca alternifolia (tea tree) oil. J. Appl. Microbiol. 2003, 95, 853–860. [Google Scholar] [CrossRef]
- Nasir, N.N.M.; Ho, C.L.; Lamasudin, D.U.; Saidi, N.B. Nitric oxide improves tolerance to Fusarium oxysporum f. sp. cubense Tropical Race 4 in banana. Physiol. Mol. Plant Pathol. 2020, 111, 101503. [Google Scholar] [CrossRef]
- Fernando, P.M.; Larissa, C.F.; Jhonata, L.S.; Leandro, P.P.; Paulo, E.S. Influence of plant extracts and essential oils against Panama disease (Fusarium oxysprum f. sp. cubense) in banana seedlings. J. Agri. Sci. 2013, 5, 1915–9752. [Google Scholar]
- Mak, C.; Mohamed, A.A.; Liew, K.W.; Ho, Y.W. Early screening technique for Fusarium wilt resistance in banana micropropagated plants. In Proceedings of the Banana Improvement: Cellular, Molecular Biology, and Induced Mutations, Leuven, Belgium, 24–28 September 2001; Science Publishers, Inc.: New York, NY, USA, 2001; pp. 219–227. [Google Scholar]

| Peak | Compound | Rt (s) | % Area | Chemical Family | Chemical Formula |
|---|---|---|---|---|---|
| 2 | á-Pinene | 180.8 | 1.80 | Monoterpene | C10H16 |
| 3 | á-Myrcene | 187.2 | 0.15 | Monoterpene | C10H16 |
| 4 | à-Phellandrene | 200.4 | 0.18 | Monoterpene | C10H16 |
| 5 | p-Menth-4(8)-ene | 210.5 | 2.89 | Monoterpene | C10H16 |
| 6 | Benzene, 1-methyl-3-(1-methylethyl)- | 217.1 | 1.79 | Monoterpenoid | C10H14S |
| 7 | Limonene | 221.2 | 2.38 | Monoterpene | C10H16 |
| 9 | Eucalyptol | 224.3 | 20.46 | Monoterpenoid | C10H18O |
| 10 | Benzene, 2-ethyl-1,3-dimethyl- | 249.3 | 7.32 | Monoterpene | C10H14 |
| 11 | γ-Terpinene | 249.5 | 7.32 | Monoterpene | C10H16 |
| 14 | p-Menth-3-ene | 280.5 | 0.38 | Monoterpene | C10H18 |
| 17 | Terpinen-4-ol | 390.0 | 22.98 | Monoterpenoid | C10H18O |
| 19 | à-Terpineol | 405.5 | 4.86 | Monoterpenoid | C10H18O |
| 22 | 1,11-Hexadecadiyne | 756.4 | 0.00 | C16H26 | |
| 25 | Androstan-17-one, 3-ethyl-3-hydroxy-, (5à)- | 836.2 | 0.56 | Steroid | C21H34O2 |
| 27 | Naphthalene, 1,2,3,5,6,8a-hexahydro-4,7-dimethyl-1-(1-methylethyl)-, (1S-cis)- | 876.2 | 0.38 | Sesquiterpene | C15H24 |
| Compound | RT (min) | m/z M-H− | Mass | Abundancy | Molecular Formula |
|---|---|---|---|---|---|
| Dihydro-jasmonic Acid, Methyl Ester | 9.831 | 249.1481 | 226.1583 | 319,221.13 | C13H22O3 |
| L-Galactono-1,4- lactone | 12.05 | 179.0545 | 178.047 | 133,254.17 | C6H10O6 |
| Diisoprop-yl sulfate | 13.157 | 205.051 | 182.0618 | 86,138.21 | C6H14 O4S |
Disclaimer/Publisher’s Note: The statements, opinions and data contained in all publications are solely those of the individual author(s) and contributor(s) and not of MDPI and/or the editor(s). MDPI and/or the editor(s) disclaim responsibility for any injury to people or property resulting from any ideas, methods, instructions or products referred to in the content. |
© 2023 by the authors. Licensee MDPI, Basel, Switzerland. This article is an open access article distributed under the terms and conditions of the Creative Commons Attribution (CC BY) license (https://creativecommons.org/licenses/by/4.0/).
Share and Cite
Paramalingam, P.; Baharum, N.A.; Abdullah, J.O.; Hong, J.K.; Saidi, N.B. Antifungal Potential of Melaleuca alternifolia against Fungal Pathogen Fusarium oxysporum f. sp. cubense Tropical Race 4. Molecules 2023, 28, 4456. https://doi.org/10.3390/molecules28114456
Paramalingam P, Baharum NA, Abdullah JO, Hong JK, Saidi NB. Antifungal Potential of Melaleuca alternifolia against Fungal Pathogen Fusarium oxysporum f. sp. cubense Tropical Race 4. Molecules. 2023; 28(11):4456. https://doi.org/10.3390/molecules28114456
Chicago/Turabian StyleParamalingam, Pavitra, Nadiya Akmal Baharum, Janna Ong Abdullah, Jeum Kyu Hong, and Noor Baity Saidi. 2023. "Antifungal Potential of Melaleuca alternifolia against Fungal Pathogen Fusarium oxysporum f. sp. cubense Tropical Race 4" Molecules 28, no. 11: 4456. https://doi.org/10.3390/molecules28114456
APA StyleParamalingam, P., Baharum, N. A., Abdullah, J. O., Hong, J. K., & Saidi, N. B. (2023). Antifungal Potential of Melaleuca alternifolia against Fungal Pathogen Fusarium oxysporum f. sp. cubense Tropical Race 4. Molecules, 28(11), 4456. https://doi.org/10.3390/molecules28114456

